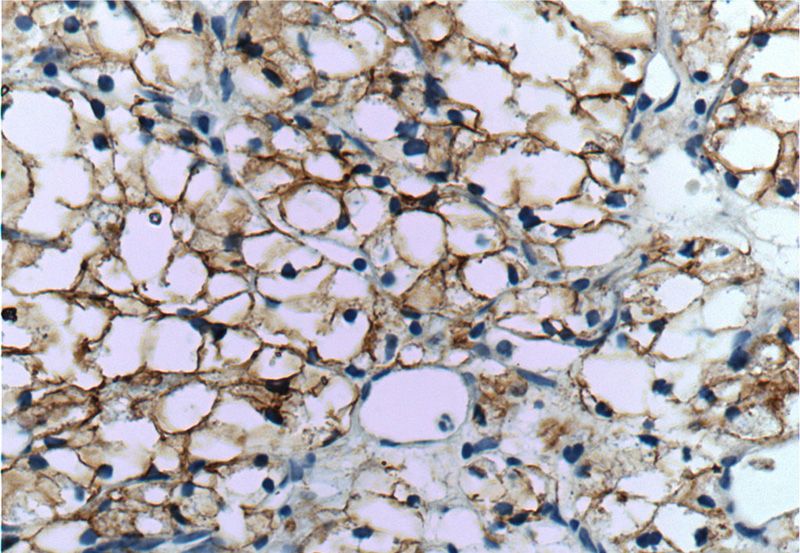
Immunohistochemistry of paraffin-embedded human renal cell carcinoma tissue slide using Catalog No:108740(CA9 Antibody) at dilution of 1:50 (under 40x lens)

-
Product Name
CA IX antibody
- Documents
-
Description
CA IX Rabbit Polyclonal antibody. Positive WB detected in HEK-293 cells, A375 cells, A431 cells, A549 cells, HeLa cells, HepG2 cells, MCF7 cells, mouse brain tissue, mouse kidney tissue, mouse skin tissue, rat brain tissue. Positive IP detected in mouse liver tissue. Positive IHC detected in human renal cell carcinoma tissue, human liver cancer tissue, human lung cancer tissue, human prostate cancer tissue, human stomach cancer tissue, human stomach tissue. Positive FC detected in HEK-293 cells. Observed molecular weight by Western-blot: 60-70 kDa
-
Tested applications
ELISA, WB, IP, FC, IHC
-
Species reactivity
Human, Mouse, Rat; other species not tested.
-
Alternative names
CA IX antibody; CA9 antibody; CAIX antibody; Carbonate dehydratase IX antibody; Carbonic anhydrase 9 antibody; carbonic anhydrase IX antibody; G250 antibody; Membrane antigen MN antibody; P54/58N antibody; pMW1 antibody; RCC assOCiated antigen G250 antibody
-
Isotype
Rabbit IgG
-
Preparation
This antibody was obtained by immunization of CA IX recombinant protein (Accession Number: NM_001216). Purification method: Antigen affinity purified.
-
Clonality
Polyclonal
-
Formulation
PBS with 0.1% sodium azide and 50% glycerol pH 7.3.
-
Storage instructions
Store at -20℃. DO NOT ALIQUOT
-
Applications
Recommended Dilution:
WB: 1:500-1:5000
IP: 1:200-1:2000
IHC: 1:20-1:200
-
Validations

HEK-293 cells were subjected to SDS PAGE followed by western blot with Catalog No:108740(CA9 antibody) at dilution of 1:1000

IP Result of anti-CA9 (IP:Catalog No:108740, 4ug; Detection:Catalog No:108740 1:500) with mouse liver tissue lysate 4000ug.

Immunohistochemistry of paraffin-embedded human renal cell carcinoma tissue slide using Catalog No:108740(CA9 Antibody) at dilution of 1:50 (under 10x lens)
Immunohistochemistry of paraffin-embedded human renal cell carcinoma tissue slide using Catalog No:108740(CA9 Antibody) at dilution of 1:50 (under 40x lens)

1X10^6 HEK-293 cells were stained with 0.2ug CA9 antibody (Catalog No:108740, red) and control antibody (blue). Fixed with 90% MeOH blocked with 3% BSA (30 min). Alexa Fluor 488-congugated AffiniPure Goat Anti-Rabbit IgG(H+L) with dilution 1:1000.
-
Background
CA9(Carbonic anhydrase 9) may be involved in the control of cell proliferation and transformation and appears to be a novel specific biomarker for a cervical neoplasia(PMID:18703501).It is a tumor-associated antigen that has been shown to have diagnostic utility in identifying cervical dysplasia and carcinoma.The protein is presentboth on the plasma membrane and in the nucleus of cells and has the molecular.It was observed the 54KDa and 58 Kda bands in A549(Joc,vol21,no.3,473-482).
-
References
- Shan X, Wang D, Chen J. Necrosis degree displayed in computed tomography images correlated with hypoxia and angiogenesis in breast cancer. Journal of computer assisted tomography. 37(1):22-8. 2013.
- Chesney J, Clark J, Klarer AC, Imbert-Fernandez Y, Lane AN, Telang S. Fructose-2,6-bisphosphate synthesis by 6-phosphofructo-2-kinase/fructose-2,6-bisphosphatase 4 (PFKFB4) is required for the glycolytic response to hypoxia and tumor growth. Oncotarget. 5(16):6670-86. 2014.
- Woolf EC, Curley KL, Liu Q. The Ketogenic Diet Alters the Hypoxic Response and Affects Expression of Proteins Associated with Angiogenesis, Invasive Potential and Vascular Permeability in a Mouse Glioma Model. PloS one. 10(6):e0130357. 2015.
Related Products / Services
Please note: All products are "FOR RESEARCH USE ONLY AND ARE NOT INTENDED FOR DIAGNOSTIC OR THERAPEUTIC USE"
